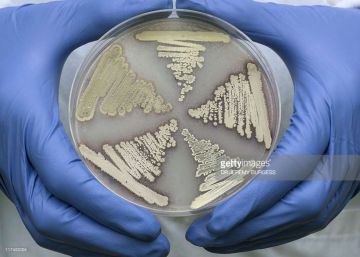
Una mutación global

Un asilo para pandas
Un centro cerca de la ciudad china de Chengdu cuida de los pandas más longevos y se convierte en un hospital para los heridos

Un centro cerca de la ciudad china de Chengdu cuida de los pandas más longevos y se convierte en un hospital para los heridos
 Ampliar foto
Ampliar foto
Su primer gran trabajo fue reducir una de las conjeturas de Langlands, de casi 300 páginas, hasta dejarla en 37

Una molécula es eficaz en ratones contra el chagas, la leishmaniasis y la enfermedad del sueño, que matan a 50.000 personas al año

Las llamadas ‘lágrimas de San Lorenzo' son en realidad pequeñas partículas de polvo de distintos tamaños

La infección por bacterias marinas ha crecido a la par que la temperatura del agua

Los indicios de algo más importante que el bosón de Higgs resultan ser un espejismo estadístico

Varios equipos científicos luchan contra reloj por conseguir una inmunización antes de que acabe la epidemia

El proyecto europeo para transformar nuestros residuos y la luz del Sol en biocombustible tiene en Chiclana su experimento más avanzado y esperanzador

En contextos competitivos y cooperativos, evaluamos nuestro desempeño influenciados por las habilidades de nuestros aliados o adversarios
 Ampliar foto
Ampliar foto
Un reloj interno marca el crecimiento desigual de los tallos que provoca el giro de las flores

La Unesco hace un llamamiento para proteger las maravillas submarinas que quedan lejos de cualquier jurisdicción nacional

Los niños de esta comunidad tradicional han desarrollado inmunidad gracias al polvo de sus casas

El proyecto europeo All-gas inicia la fase de demostración en los cultivos de microalgas en aguas residuales para generar biocombustible

Un empresario obtiene el permiso del Gobierno para llevar cenizas humanas y otros objetos al satélite

La era de Fleming puede estar tocando a su fin. Y aún no tenemos un buen relevo

Jesús Rodríguez Baño es el coordinador de la Red Española de Investigación en Patología Infecciosa (REIPI), una organización para luchar contra la resistencia de los microbios

La capacidad de adaptación de las bacterias, el mal uso en granjas, la globalización y un problema de mercado hacen peligrar la eficacia de los antimicrobianos
La resistencia a los antimicrobianos no es sólo un problema de salud, sino también económico. EE UU y Reino Unido han establecido una hoja de ruta para esta crisis

'Materia' desafía a sus lectores a resolver este tercer desafío científico, que acompaña a la biblioteca 'Descubrir la ciencia'.
 Ampliar foto
Ampliar foto
¿Qué tienen los cachalotes en la cabeza? De todo y más para relacionarse, cazar y ¡luchar!
Aristóteles quedó fascinado con la danza de estos insectos, y Karl von Frisch ganó el Premio Nobel por descifrar su significado

Las matemáticas tienen gran influencia en las expresiones y el habla cotidiana

La divulgación de las matemáticas y el futuro de las revistas científicas, a debate en el Séptimo Congreso Europeo de Matemática, que se desarrolla en Berlín

Una visión matemática que explica qué hubiera sucedido en las elecciones del 26J si se hubiera hecho el reparto por autonomías usando el método D’Hont o el Sainte-Laguë
 Ampliar foto
Ampliar foto
En un universo infinito y homogéneo, todo lo que no es imposible existiría realmente, y además, infinitas veces

¿Existe en el mundo físico algo que no tenga principio ni fin, o el infinito solo es un concepto matemático?

¿Es infinito el número de libros escribibles? ¿Y el número de cuadros pintables?

Diagonales finitas que nos conducen al infinito. Diagonales infinitas que nos llevan aún más lejos…

La corriente transhumanista propone alcanzar la 'inmortalidad' conectando nuestras mentes a las máquinas

La capacidad de adicción de una droga depende de diversas circunstancias, como la activación del sistema de la dopamina del cerebro o la sensación de placer
 Ampliar foto
Ampliar foto
Monos de un parque natural de Gambia portan una bacteria transmitida por los turistas

Los geólogos descubren evidencias de la Gran Inundación que originó la civilización china

Arranca en EE UU el primer ensayo de una inmunización contra el virus que ha causado más de 1.700 casos de malformación en fetos

Los criollos, derivados de las razas llegadas a partir de 1493, están en peligro de extinción. Un gran proyecto internacional identificará, mediante la genética, cuáles conservar

Cuatro copias exactas del primer mamífero nacido por transferencia nuclear llegan a viejos sin envejecimiento acelerado ni enfermedades
Varios estudios dan nuevas claves sobre cómo las hembras de bonobo sostienen su sociedad tolerante

Las causas del hambre en el mundo son políticas. Poco puede hacer la tecnología genética para acabar con la desnutrición si se transforman los modelos socio-productivos